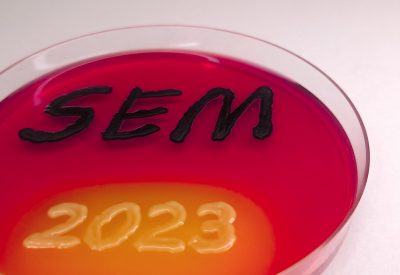
17-Salmonella y E. coli unidas en la SEM

Salmonella y E. coli unidas en la SEM
Publicada el 9/03/2026
Título: Salmonella y E. coli unidas en la SEM
Autor: María Gil Molino
Universidad de Extremadura. Facultad de Veterinaria. Avda. Universidad s/n. 10003, Cáceres
Descripción: Medio de cultivo XLD donde la palabra SEM es una cepa de Salmonella typhimurium y el año 2023 es una cepa de E. coli.